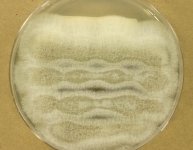

Search Details
| UAMH Number: | 8496 |
|---|---|
| Species Name: | Scedosporium apiospermum |
| Type: | |
| Synonyms: | Acremonium suis / Actinomyces albus / Actinomyces tarozzii / Aleurisma apiospermum / Dendrostilbella boydii / Glenospora clapieri / Glenosporopsis clapieri / Indiella americana / Madurella americana / Madurella clapieri / Monosporium apiospermum / Monosporium apiospermum var. peperei / Monosporium sclerotiale / Polycytella hominis / Scedosporium sclerotiale / Streptothrix tarozzii / Trichosporum clapieri |
| Taxonomy: | FUNGI Ascomycota, Sordariomycetes, Microascales, Microascaceae |
| Strain History: | G. Okada (OFC 1384) -> Nakase, T. (JCM 7866) -> UAMH |
| Substrate: | grass | Location: | JAPAN Ibaraki, Tsukuba (GEO: 36.083,140.077) |
| Isolator: | G. Okada (OFC 1384) |
| Isolation Date: | |
| Date Received: | 1996-06-28 |
| Characters: | CULTURE CONDITIONS produced Scedosporium and Graphium states but no ascomata // MOLECULAR SYSTEMATICS Blast match 100% ITS similarity to CBS 101.22 (UAMH 3982) T Pseudallescheria boydii and dissimilar to HQ185348 Parascedosporium putredinis epitype - fide UAMH 2012 // MOLECULAR SYSTEMATICS Formerly identified as Graphium putredinis (Parascedosporium putredinis) |
| Compounds: | |
| Cross Reference: | CBS 102081 // JCM 7866 |
| Pathogenic Potential: | Human: yes | Animal: yes | Plant: no |
| Biosafety Risk Group: | RG2 (check the PHAC ePATHogen Risk Group Database for updates) |
| Regulatory Requirements: | Canadian requesters must provide PHAC Pathogen and Toxin License Number (see: https://www.canada.ca/en/public-health/services/laboratory-biosafety-biosecurity/licensing-program.html) and a CFIA Written Authorization for transfer (http://www.inspection.gc.ca/plants/plant-pests-invasive-species/directives/date/d-12-03/eng/1432656209220/1432751554580#app2) prior to shipment. International requesters must provide all legally required importation documentation prior to shipment. Plant pathogenicity status may be verified by using the USDA Agricultural Research Service (ARS) Fungal Database |
| MycoBank ID: | 432048 |
| Sequences: | >UAMH08496_ITS CATTACAGAGTTACTACTCCAAACCCATTGTGAACCTTACCTATGTTCTGTTGCCTCGGCGGCGTCGGTCAGCGCCCCTCTGAAAAGAGGACGATGCCCCTCCCGCCGGCAGCACCAAACTCTTGAATTTTACAGCGGATTACAGTTCTGATTTGAAAACAAAAAACAAGTTAAAACTTTCAACAACGGATCTCTTGGTTCTGGCATCGATGAAGAACGCAGCGAAATGCGATAAGTAATGTGAATTGCAGAATTCAGTGAATCATCGAATCTTTGAACGCACATTGCGCCCGGCAGTAATCTGCCGGGCATGCCTGTCCGAGCGTCATTTCAACCCTCGAACCTCCGTTTCCTTAGGGAAGCCTAGGGTCGGTGTTGGGGCGCTACGGCGAGTCCTCGCGACCCCCGTAGGCCCTGAAATACAGTGGCGGTCCCGCCGCGGTTGCCTTCTGCGTAGTAAGTCTCTTTTGCAAGCTCGCATTGGGTCCCGGCGGAGGCCTGCCGTCAAACCACCTAACAACTCCAGA >UAMH08496_AB007683_SSU TCATATGCTTGTCTCAAAGATTAAGCCATGCATGTCTAAGTATAAGCAATTATACCGCGAAACTGCGAATGGCTCATTATATAAGTTATCGTTTATTTGATAGCACATTACTACATGGATAACTGTGGTAATTCTAGAGCTAATACATGCTAAAAATCCCGACTTCGGAAGGGATGTATTTATTAGATTAAAAGCCAACGCCCTTCGGGGCTTCGTGGTGATTCATGATAACTTTTCGAATCGCATGGCCTTGCGCCGGCGATGGTTCATTCAAATTTCTTCCCTATCAACTTTCGATGCGAAGGTCTTGTCTTCGCATGGTTGCAACGGGTAACGGAGGGTTAGGGCTCGACCCCGGAGAAGGAGCCTGAGAAACGGCTACTACATCCAAGGAAGGCAGCAGGCGCGCAAATTACCCAATCCCGACACGGGGAGGTAGTGACAATAAATACTGATACAGGGCTCTTTTGGGTCTTGTAATCGGAATGAGTACAATTTAAATCCCTTAACGAGGAACAATTGGAGGGCAAGTCTGGTGCCAGCAGCCGCGGTAATTCCAGCTCCAATAGCGTATATTAAAGTTGTTGTGGTTAAAAAGCTCGTAGTTGAACCTTGGGGCTGGCTGGCCGGTCCCCCTCACCGGGTGCACTGATCCAGCCGGGCCTTTCCCTCTGTGGAACCCCATGGCCTTCACTGGCCGTGGCGGGGAAACAGGACTTTTACTTTGAAAAAATTAGAGTGCTCCAGGCAGGCCTATGCTCGAATACATTAGCATGGAATAATAGAATAGGACGTGTGGTTCTATTTTGTTGGTTTCTAGGACCGCCGTAATGATTAATAGGGACAGTCGGGGGCATCAGTATTCAATTGTCAGAGGTGAAATTCTTGGATCTATTGAAGACTAACTACTGCGAAAGATTTGCCAAGGATGTTTTCATTGATAAGGAACGAAAGTTAGGGGATCGAAGACGATCAGATACCGTCGTAGTCTTAACTATAAACTATGCCGACTAGGGATCGGACGATGTTATTTCTTGACGCGTTCGGCACCTTTCGAGAAATCAAAGTGCTTGGGCCCCAGGGGAGTATGGTCGCAAGGCTGAAACTTAAAGAAATTGACGGAAGGGCACCACCAGGGGTTAACGTCTAACTGTTAAGCCACAGAAGAAATCTGCTCCTGAAAGCCGCCCGAAAGGGTGAGGTGGTGTCCGGAGCGTGCGAGCTCGAATTTAAAGGCTAGTCCTCCAATGCGGAGGGCGACATCCTCAAATTGCGGGGAACTCCTAAAGCTTTAACTCCAAAGCCGGTTCGCGAAAGCCGCCGGTGGCCAGGTTAACAGCCTCGGGTACTGGAAAAACGTGGAAGATGCGACAATGGACAATCCGCAGCCAAGCCCCTAAAGGCTCCCCGTCGAGGGACGCCCACGGGGAAGGTTCAGAGACTTAACGGGGATGGGTATTCGCCGAGAGGCGCCTGCTTAAGATAAAGTCCGGCCCTGCGCGAGAGCGCGGGGGTAGCAGGGAACTGCGGCTTAATTTGACTCAACACGGGGAAACTCACCAGGTCCAGACACAGTGAGGATTGACAGATTGAGAGCTCTTTCTTGATTCTGTGGGTGGTGGTGCATGGCCGTTCTTAGTTGGTGGAGTGATTTGTCTGCTTAATTGCGATAACGAACGAGACCTTAACCTGCTAAATAGCCCGTACTGCTTTGGCAGTTCGCCGGCNTCTTAGAGGGACTATCGGCTCAAGCCGATGGAAGTTTGAGGCAATAACAGGTCTGTGATGCCCTTAGATGTCCTGGGCCGCACGCGCGTTACACTGACAGAGCCAGCGAGTATTTCCTTGGCCGGAAGGCCCGGGTAATCTTGTTAAACTCTGCCGTGCTGGGGATAGAGCATTGCAATTATTGCTCTTCAACGAGGAATCCCTAGTAAGCGCAAGTCATCAGCTTGCGTTGATTACGTCCCTGCCCTTTGTACACACCGCCCGTCGCCTCTACCGATTGAATGGCTCAGTGAGGCCTCCGGACTGGCCCAGAGAGGTGGGCAACTACCACTCAGGNNNGGAAAGTTGTCCAAACTCGGTCATTTAGAGGAAGTAAAAGTCGTAACAAGGTCTCCGTT |
IMAGES: